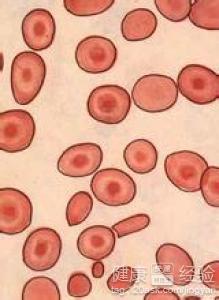
第3步

寶寶缺鐵性貧血怎麼辦
概 述
鐵在我們的身體中原本是有非常重要的一個地位,他可以幫助我們身體提供紅細胞,這樣子我們就可以得到身體需要的血液了,但是當鐵消耗完了以後患者就不可以正常的得到供血,這個時候我們把這種情況叫做缺鐵性貧血,而因為寶寶身體當中原本存儲的鐵就不多,因此如果營養方面沒有跟上的話很容易會出現這種疾病,這個時候要及時的進行治療。
步驟/方法:
1首先是進行藥物治療,藥物治療主要是對含有鐵元素的藥物進行口服,一般來說一次服用的計量為150ML到200ML,但是因為孩子的吸收功能比較差,不可以把服用下去的鐵全部吸收。
2因此孩子大部分使用的方法都是飲食療法,而藥物治療的藥物主要是亞鐵制劑,一般來說服用了3到4天以後患者的身體就會開始出現好轉的情況,連續服用兩個月疾病基本上就痊愈了。

3最後是飲食療法,孩子患上了這種疾病以後病情是不會特別的嚴重,及時的調整飲食病情就不會在惡化,所以需要進食含鐵豐富的食物、高蛋白飲食、吃一些含有維生素比較豐富的食物等。
注意事項:
孩子出現了這種疾病的話家長是一定要特別關心的,如果長時間下來沒有治療可能就會導致患者的病情不斷的惡化,到最後甚至影響到患者的成長。
- 上一頁:寶寶上睑下垂如何治療
- 下一頁:寶寶腦震蕩怎麼辦
- 關於0到1歲知識
-
寶寶一歲五個月了還不愛說話怎麼辦
寶寶一歲五個月了還不愛說話
-
一歲寶寶老是睡不好該怎麼辦呀?
一歲寶寶老是睡不好該怎麼辦
-
昨天晚飯吃烤腸,今天拉肚子
昨天晚飯吃烤腸,今天拉肚子
-
蛋黃過敏能打麻疹疫苗嗎?
網友hope426 :劉





